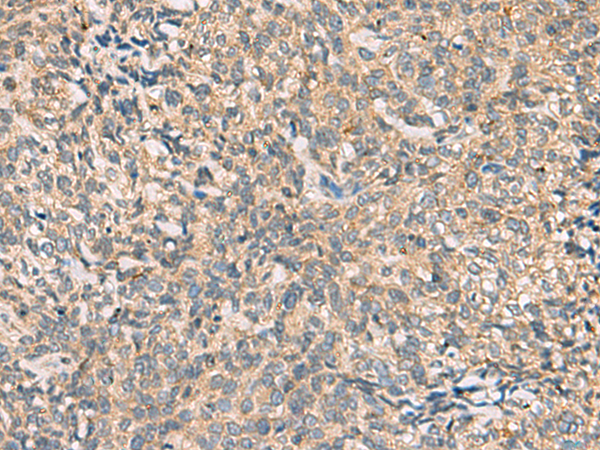

|
Background: |
This gene belongs to the chemokine-like factor gene superfamily, a novel family that is similar to the chemokine and the transmembrane 4 superfamilies of signaling molecules. This gene is one of several chemokine-like factor genes located in a cluster on chromosome 16. Alternatively spliced transcript variants encoding different isoforms have been identified. |
|
Applications: |
ELISA, IHC |
|
Name of antibody: |
CMTM4 |
|
Immunogen: |
Synthetic peptide of human CMTM4 |
|
Full name: |
CKLF like MARVEL transmembrane domain containing 4 |
|
Synonyms: |
CKLFSF4 |
|
SwissProt: |
Q8IZR5 |
|
ELISA Recommended dilution: |
5000-10000 |
|
IHC positive control: |
Human cervical cancer and Human tonsil |
|
IHC Recommend dilution: |
50-200 |

購(gòu)物車
購(gòu)物車 幫助
幫助
 021-54845833/15800441009
021-54845833/15800441009
